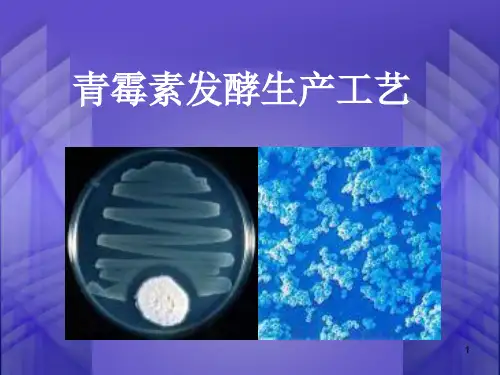

返27 回
染菌的处理
• ⒊发酵中期染菌
发酵中期染菌将严重干扰生产菌的代谢,影 响产物的生成。如产酸,产泡沫,使菌体自溶, 使发酵液变臭等。发酵中期染菌,由于营养成分 大量消耗,一般挽救处理困难,危害性大,发酵 中期染菌应做到早发现,早处理,通常做法是 “倒罐”,即用一罐没有染菌的发酵液与染菌的 发酵液混合,使有害菌浓度下降,生产菌浓度提 高进而重新成为优势生长菌群。显然,倒罐必然 造成物料消耗和操作费用的增加。
6.泡沫的控制 :
在发酵过程中产生大量泡沫, 可以用天然油脂, 如豆油、 玉米油等或用化学合成消泡剂 “ 泡敌 ” 来消泡。
应当控制其用量并要少量多次加入, 尤其在发酵前期 不宜多用, 否则会影响菌体的呼吸代谢 。
加消沫剂控制泡沫,必要时还加入酸、碱以调节发 酵液的pH。
23
染菌处理
染菌是发酵工业长期以来不能彻底解 决的问题,因此如何解决染菌问题就成了 发酵工业的工作重点之一。要解决染菌问 题首要问题就是要能检测出是否染菌。
种子培养主要是生长繁殖菌体。此时菌体浓 度低,培养基营养丰富,因此容易染菌。种子培 养期染菌,带进发酵罐中的危害极大,应严格控 制种子污染。当发现种子受污染后均应灭菌后弃 去,并对种子罐、管道进行检查和彻底灭菌。
返26 回
染菌的处理
• ⒉发酵前期染菌
发酵前朗主要是菌体生长繁殖,代谢产物生 成很少,染菌后杂菌容易繁殖,与生产菌争夺营 养成分和氧分,严重干扰生产菌的生长繁殖和产 物的生成,因此要特别注意发酵前期的染菌。当 发酵前期染菌时,由于营养成分消耗不多,能耗 也不大,从经济性的角度考虑应迅速重新灭菌, 补充必要的营养成分,重新接种进行发酵。
青霉素发酵生产工艺
1
➢青霉素发酵生产工艺 菌种 发酵工艺流程 培养基 发酵培养控制 提取精制